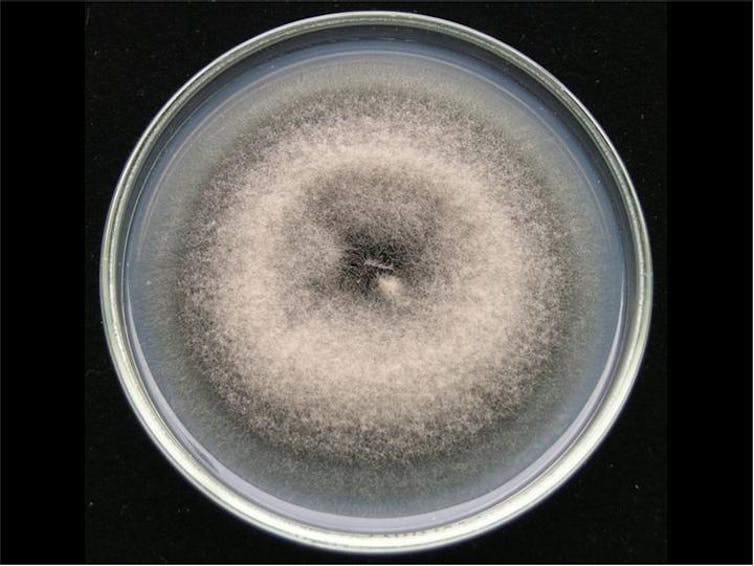

La UVa renueva su acreditación como miembro de la Red de Unidades de Cultura Científica de la FECYT
La Universidad de Valladolid reafirma de este modo su compromiso con el fomento de la cultura científica y tecnológica a través de su UCC+I
La Unidad de Cultura Científica y de la Innovación (UCC+I) de la Universidad de Valladolid (UVa) ha cumplido con éxito los requisitos para renovar su registro en la RedUCC+I de la Fundación Española para la Ciencia y la Tecnología (FECYT) por dos años, hasta diciembre de 2026, según la resolución publicada por esta fundación pública. Esta acreditación reafirma el compromiso de la UVa con el fomento de la cultura científica a través de este servicio universitario.
La unidad, dependiente del vicerrectorado de Investigación, ha cumplido en el proceso de evaluación con los requisitos establecidos por esta organización dependiente del Ministerio de Ciencia, Innovación y Universidades. Desde su registro en 2019 en esta red, la UCC+I de la UVa ha superado cada periodo de renovación con solvencia.
Un total de 111 organizaciones españolas disponen en la actualidad de estos servicios especializados, nodos de una tupida maya destinada a hacer llegar la investigación a la ciudadanía. El procedimiento de acreditación o renovación en la Red de Unidades de Cultura Científica y de la Innovación (RedUCC+I) se publica en el Boletín Oficial del Estado (BOE) cada año desde 2024. Superarlo acredita la condición de miembro en la RedUCC+I por dos años. La resolución provisional ha sido publicada el 23 de junio de 2025 tras el informe firmado de un comité de evaluación, formado por tres especialistas en comunicación social de la ciencia
El vicerrector de Investigación, Enrique Baeyens, ha valorado la renovación como “un paso más en la consolidación de la actividad de la Unidad de Cultura Científica y de la Innovación en la Universidad de Valladolid” y recuerda “la creciente importancia que está adquiriendo la difusión de la labor investigadora, entendida como transferencia social del conocimiento, en el desarrollo de la carrera profesional del personal investigador; y de las estructuras que facilitan esta actividad”.
Cuatro actividades de divulgación científica de la Unidad de Cultura Científica y de la Innovación de la Universidad de Valladolid. De izquierda a derecha, Noche Europea de l@s Investigador@s, Lo que no te contaron los cuentos clásicos, El legado del Premio Nobel, Día Internacional de la Mujer y la Niña en la Ciencia
¿Qué es una UCC+I?
Las unidades de Cultura Científica y de la Innovación (UCC+I), como la de la Universidad de Valladolid, son las intermediarias entre las instituciones que las acogen y la ciudadanía, con el objetivo principal de promocionar la cultura científica, tecnológica y de la innovación. Lo hacen a través de actividades de diversa tipología: generan comunicación de resultados de I+D+I, realizan divulgación del conocimiento científico y tecnológico, forman al personal investigador de la entidad en habilidades comunicativas y divulgativas, generan conocimiento sobre comunicación social de la ciencia.
Desde que se pusieron en marcha en 2007, estas estructuras han permitido a sus instituciones profesionalizar y coordinar la actividad divulgadora con personal técnico especializado al servicio tanto de la comunidad investigadora como de la sociedad. Para ser considerada como UCC+I, las organizaciones deben cumplir una serie de requisitos mínimos establecidos por FECYT, referidos a su presupuesto, su personal y a un cumplimiento de estándares e indicadores en las acciones divulgativas desarrolladas.
En la UVa
La Unidad de Cultura Científica de la Universidad de Valladolid es un servicio dependiente del vicerrectorado de Investigación desde su creación. Entre otras funciones, es la encargada de organizar y coordinar las actividades divulgativas de la institución, como por ejemplo la Noche Europea de l@s Investigador@s, la Semana de la Ciencia en la UVa o el Día Internacional de la Mujer y la Niña en la Ciencia. Además, desarrolla actividades divulgativas propias de carácter innovador y participa en actividades conjuntas con otras UCC+I u otras estructuras de la universidad.
Está presente en la RedUCC+I de FECYT, en la Red de Divulgación y Cultura Científica (RedDivulga) de Crue Universidades Españolas y en el desarrollo de la red autonómica de unidades de Cultura Científica y de la Innovación de las universidades públicas de Castilla y León.
La UCC+I de la UVa dispone de un site propio (ucc.uva.es), así como de perfiles en los medios sociales Twitter, Instagram, Bluesky y Threads (en todos, bajo el usuario @UVadivulga).